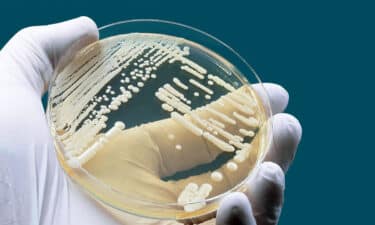

Mantar Enfeksiyonları Kansere Neden Olabilir! Candida Mantarı Tehlikesi

Mantar enfeksiyonları Kansere neden olur mu? bu yazımızda bu sorunun cevabını arıyor olacağız. Kanser tanılarının sayısı son yıllarda ciddi şekilde artış göstermekte, hastalık şimdi Amerika Birleşik Devletleri’nde bir numaralı katil rahatsızlık olarak neredeyse kalp rahatsızlıklarının önüne geçmiştir.
Şuan da her 3 kişiden biri kanser riski taşımakta. Son veriler ayrıca kanserin yılda en az 576,691, ya da TÜM ölümlerin yaklaşık % 23’ünü oluşturduğunu göstermiştir.
- Candida Mantarı Belirtileri ve Tedavisi Nelerdir? Nasıl Beslenmeli?
- Candida Mantarı: Candida Auris Tehlikeleri Belirtileri ve Tedavisi
Uzmanlar genellikle sigara ve alkol gibi bariz sağlıksız yaşam tarzı tercihlerinin yanı sıra, çoğu zaman kanserin gerçek nedenini bilemiyorlar.
Bununla ilgili farklı bilimsel görüşler olsa da, bu ölümcül hastalık için olası bir neden olarak, bir mantar enfeksiyonunun neden olduğuna dair yeni bir fikir ortaya çıkmıştır.
İçindekiler
Mantar Enfeksiyonu Kansere Neden Olabilir

Ev Medikal Ansiklopedisi’ne(The Home Medical Encyclopedia) göre, 1963’te tüm Amerikalıların yaklaşık % 50’si “tanınmayan” sistemik bir mantar enfeksiyonu geçirdi.
Bu enfeksiyonun nedenini, bazıları antibiyotiklere, doğum kontrol haplarına, aşırı işlenmiş şeker ve tahıl tüketimine, ağır metal kontaminasyonuna, ksenoöstrojenlere, alkole, sigaraya ve kronik stres olmak üzere çeşitli faktörlere bağlamıştır.
Bu faktörler, aktif enzimler ve probiyotiklerden ciddi ölçüde eksik olan diyetlerle birleştiğinde, bugüne kadarki en yaygın mantar enfeksiyonlarından biri olan Candida albicans’ın yolunu açmıştır.
Candida Mantarı’nın Belirtileri
Candida Albicans, kontrol altındayken hiçbir sorun yaşamaz, hatta ondan yararlanırız. Gel gelelim, yaşam kalitemizde sapmalar olur ve biz bunları düzeltmek için çaba sarf etmezsek işler çığırından çıkabilir, Candida mantarı belirtileri ortaya çıkar ve Candida kontrolden çıkar.
Candida Mantarı Belirtileri
- Sporcu ayağı
- Bebeklerde pişik, pamukçuk.
- Elmacık kemiklerinde ve alında hassasiyet ve ağrı.
- Ellerde ve ayaklarda üşüme, vücut ısısında düşüş.
- Üşütmüş gibi hissetmek. Sinüslerin, burun, boğaz ve ciğerlerin mukusla dolması.
- Aşerme veya bağımlılık derecesinde şeker, ekmek, makarna gibi yüksek karbonhidrat içeren gıdaları hatta alkol istemek.
- Boyun, boğaz, yumurtalık bölgesi, mesane, erbezi torbası gibi bölgelerde kist veya formal değişimler.
- Kulaklarda çınlama, ses duyma, iltihaplanma, kuruluk ve kaşıntı, ağrı, acı hissi, kulak akıntısı, içeride sıvı birikmesi, duyma bozukluğu, aşırı kulak kiri birikmesi.
- Gözlerde; görüş bozukluğu, uçuşan noktacıklar, ışık çakması, kızarıklık, kuruluk, kaşıntı, aşırı göz yaşarması gibi problemler.
- Bezlerde şişkinlik; ağız kuruluğu, tükürük bezlerinde tıkanıklık, lenf bezlerinde şişkinlik.
- Kalp çarpıntısı, kalpte düzensiz atış.
- Baş ağrısı, migren, baş dönmesi.
- Hemoroid, anüste kaşıntı ve kızarıklık, pişik.
- Düşük şeker (hipoglisemi) ve diyabet.
- Hipotiroid, Wilson tiroid sendromu, Haşimato hastalığı, hiper tiroid, düzensiz tiroid hareketleri vs.
- Eklem ağrıları, sertleşme yada şişkinlik (artrit)
- Kaslarda; ağrılar, uyuşukluk, yanma veya karıncalanma, koordinasyon bozukluğu ve güç eksikliği.
Solunum Yollarında Candida Mantar Belirtileri
- Sinüs iltihaplanması, şişme ve enfeksiyonlar.
- Solunum sistemi; öksürük, bronşit, zatürre, hırıltı, göğüs ağrısı ve sıkışması, nefes daralması, astım.
- Boğaz ağrısı, seste çatallanma, boğazda durmadan gıcıklanma, ses kaybı, vs.
- Burun tıkanıklığı, burun akıntısı, burunda kaşıntı, kuruluk.
- Gribal belirtiler
- Saman nezlesi ve astım.
Sindirimde Candida Mantar Belirtileri
- Ağızda; yaralar ve ağrılar, aft, nefesin kötü kokması, ağız içinde beyaz lekeler (pamukçuk).
- Midede; Helikobakter pilori enfeksiyonu (ülsere neden olur), mide yanması, hazım problemi, reflü, kusma, mide ağrısı, iğne batma hissi, yenilen yemeğin mideye oturması, mide fıtığı, gaz çıkarmak, geğirmek.
- İştahsızlık
- Böbrek ve mesanede; enfeksiyon, sistit, idrara çok sık çıkma veya sıkışma hissi, az idrar gelmesi, idrarda koku, idrara çıktığında yanma hissi.
- Sindirim problemleri; ishal, kabızlık, karın bölgesinde şişkinlik ve ağrı, gaz, dışkıda mukus, ülser v.b…
Candida Mantarı Ruhsal Belirtiler
- Uyku; İnsomnia, sık sık uyanma, kabus, uykuda dinlenememe.
- Akıl ve ruh sağlığı; anksiyete atakları, ağlama krizi, hafıza kaybı, boşlukta hissetme, depresyon (intihara eğilimli olmak da dahil), manik duygular, konsantrasyon bozukluğu, ruh halinde hızlı değişiklikler, huysuzluk vb.
- Kronik yorgunluk, enerjisi çekilmiş gibi hissetme, uyuşukluk, rehavet.
- Huzursuzluk, sinirlilik, panik atak.
Cilt ve Saç ile ilgili Candida Belirtiler
- Darbelerde cildin kolayca morarması
- Saç dökülmesi, kepek, saç diplerinde kaşıntı, ağrı, kuruluk.
- Deride; kuruluk, kırmızı lekeler, akne, sivilce, kurdeşen, kızarıklık, kaşıntı, egzama, sedef hastalığı, ayak mantarı, sebora (bir tür egzama), gül hastalığı (virütik, döküntülü bir cilt hastalığı) gibi.
- Deride doku bozulması, bazen de iç organlarda bozulmalar. Mesela, beyin dokusunda bozulmalar.
- Deride ve tırnaklarda; mantar enfeksiyonu, açık veya koyu renk lekeler.
- Deride doku bozulması, bazen de iç organlarda bozulmalar. Mesela, beyin dokusunda bozulmalar
- Ayak kokusu, yıkanmayla geçmeyen vücut ve saçta koku problemi
Alerjik Candida Belirtileri
- Alerjiler, rutubetli ve yağmurlu havalarda kötüleşen hassasiyetler ve intoleranslar.
- Parfüm, koku, yumuşatıcı, çimen, kedi, köpek, diğer evcil hayvanlar, sigara dumanı, kimyasallar, küfler, toz, polenler, sis, pus ve havada uçuşan maddelere karşı allerjik reaksiyonlar ve aşırı hassasiyet.
Kadınlara Özel Candida Belirtileri
- Kısırlık,
- kötü koku,
- düzensiz ve ağrılı regl,
- kramplar,
- regl öncesi mod değişiklikleri,
- akıntı,
- cinsel ilişkide ağrı veya acı,
- cinsel istekte azalma,
- genital bölgede şişkinlik ve kızarıklık,
- vajinal kaşıntı ve pişikler,
- yanma hissi yada inatçı enfeksiyonlar.
Erkeklere Özel Candida Belirtileri
- genital kaşıntı,
- cinsel istekte azalma,
- ereksiyon problemi,
- prostat,
- penis enfeksiyonları,
- işemede zorluk çekme,
- idrarda sıklık veya sıkışıklık hissi,
- cinsel ilişkide ağrı, veya acı,
- er bezi torbalarında şişkinlik
Candida Mantarı Kansere Neden Olur Mu?
Robert Young’a göre, “Bakteriler, mayalar / mantarlar ve küfler kanserli bir durumun sebebi değildir, ancak bu problemler sağlıklı bir durumdan sağlıksız bir duruma dönüşen hücrelerin ve dokuların sonucu ve kanıtıdır.”
Ayrıca, “vücudun aşırı asitlenmesinin, kronik maya ve mantar enfeksiyonlarının gelişmesine ve bunun sonucunda hücrelerin ve dokuların kanserli bir duruma dönüşebileceği” gözlemlemiştir.
Oksijen Kanser Hücrelerinin Düşmanı
Bu teoriyi desteklemek, Candida gibi mayaların anaeroblar olduğu anlayışıdır, yani oksijen yokluğunda enerji üretirler. Kan akışında, vücudun belirli bölgelerini kolonize edebilir ve oksijen seviyelerini azaltabilirler.
Sonuç olarak, yerel hücreler enerji sistemlerini oksijenden, hiç oksijen kullanmayana çevirir. İki kere ikiyi henüz bir araya getiremediyseniz, 1931’de Otto Warburg’a, oksijenin kanser hücrelerinin düşmanı olduğunu savunduğu için bir Nobel Ödülü verildiğini hatırlayın.
Candida enfeksiyonu yararlı bakterilerin işlevini bozabilir

Ayrıca, bağırsaklarınızda ki yararlı bakterilerin, bağışıklık sistemi sağlığınızın yüzde 85’i kadarını, kanser karşıtı vitaminleri beslenmenizden çıkarmanız taktirde ve hatta kanser hücrelerine neden olan bir bileşik olan (sodyum bütirat) üretmeye başladıkları bilinmektedir. Sistemik bir Candida enfeksiyonu yararlı bakterilerin işlevini ciddi şekilde bozabilir.
Johns Hopkins, ayak tırnağı mantarını tedavi etmek için yaygın olarak kullanılan bir ilaç olan itrakonazolün, anjiyogenezi (fizyolojik bir süreç olup, var olan damarlardan tomurcuklanma yolu ile yeni damarların oluşması, gelişmesi anlamına gelir.) de engelleyebildiğini, metastazlara (tüm vücut boyunca kanserin yayılmasına) olanak sağlayan yeni kan damarlarının büyümesini engelleyebileceğini buldu.
Mayo Clinic, kanserin bir mantardan kaynaklanabileceğini veya geç evre fungal enfeksiyonlarından da kaynaklanabileceğini de doğrulamıştır.
Kanser Prevalansı Sürpriz Mi?
(Prevalans: Belirli bir nüfusta, belirli bir zaman dilimi içerisinde, çalışma kapsamında yer alan, belirli bir hastalık veya hastalıklara sahip tüm olguların oranıdır.)
Candida’nın aşırı büyümesini kolaylaştıranlar
- Antibiyotik (veya herhangi bir reçeteli ilaç) kullanıyor musun?
- Doğum kontrol hapı kullanıyor musun?
- Organik olmayan gıdaları, şekerleri, tahılları(özellikle glüten içerenleri) ve nişastaları (patates gibi) tüketiyor musun?
- Metal diş dolguları yaptırıp, aşı olup, civaya maruz kaldın mı?
- Plastik kaplarda ki içecekleri ve yiyecekleri tüketiyor musun?
- Düzenli olarak bira, şarap veya sert alkol içiyor musun?
- Günlük olarak tükettiğin kafein miktarı?
- Sigara kullanıyor musun?
Bu olgulardan herhangi biri, Candida’nın aşırı büyümesini kolaylaştırabilir. Ayrıca, sistemik bir Candida enfeksiyonu kolayca düzeltilemez – yaşam tarzınızdaki son değişiklikler enfeksiyona yakalandıktan sonra size yeterince yardımcı olamaz.
Sağlıklı bir yaşam tarzı ve Candida’yı tamamen ortadan kaldırmak için enzimler ve probiyotik gıdalar açısından zengin bir beslenmeye geçseniz dahi kesin tedavi yıllarınızı alabilir.
Önlem almak tedaviden daha etkilidir
“Önlem almak tedaviden daha etkilidir” derler. Klişe ya da değil, bu sözün arkasında ki fikir her zaman doğru olacaktır. Candida hakkında daha fazla bilgi edinmek ve nasıl önleneceğini öğrenmek için üzerinize düşünleri eksiksiz yapmalısınız.
Sağlıklı bir yaşam tarzı belirleyin ve elbette, temiz ve sağlıklı yaşam hakkında en son haberleri takip ederek kendiniz eğitin.